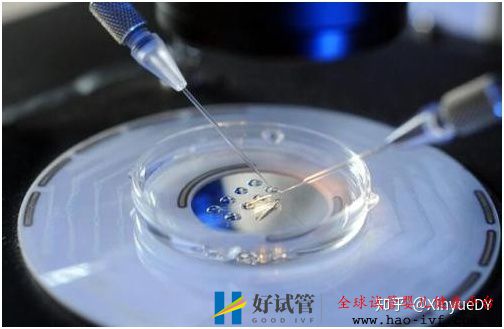
详解第一代、第二代、第三代试管婴儿以及适应症,...(图3)

详解第一代、第二代、第三代试管婴儿以及适应症,...
对于不熟悉辅助生育技术的患者来说可能并不了解试管婴儿的适应症及具体方案的选择,如不知道自己是做第一代试管婴儿还是第二代试管婴儿,甚至有的患者以为试管婴儿技术级别越高成功率越高,其实这是不对的。是第一代、第二代还是第三代试管婴儿,主要区别是适应的患者不同,今天就和大家说一下这三种技术及适应症、禁忌症。

第一代试管婴儿(IVF)
是我们所说的常规试管婴儿,是将不孕症患者夫妇的卵子与精子取出体外,精子经过洗涤后使卵子在体外系统中受精并发育成胚胎后,将胚胎移植入子宫腔内以实现妊娠的技术。这个过程中卵子的受精接近于自然妊娠的卵子受精。
1、女方各种因素导致的卵子运送障碍:如双侧输卵管阻塞、输卵管缺如、严重盆腔粘连等输卵管丧失功能者;
2、排卵障碍:难治性排卵障碍经反复常规治疗,如反复诱发排卵或结合宫腔内人工授精治疗后仍未获得妊娠者;
3、子宫内膜异位症:子宫内膜异位症经常规药物或手术治疗仍未获得妊娠者;
4、男性因素的不孕症:男性少弱畸精子症或复合因素的男性不育,经宫腔内人工授精治疗仍未获得妊娠,或男方因素严重程度不适宜行宫腔内人工授精者;
5、免疫性不孕与不明原因不孕:反复经宫腔内人工授精治疗或其他常规治疗仍未获得妊娠者等情况。
第二代试管婴儿(ICSI)
卵细胞浆内单精子注射,是将单个精子通过显微注射的方法注入卵母细胞浆内,从而是使精子和卵母细胞被动结合受精,形成受精卵并进行胚胎移植,达到妊娠的目的。
1、严重的少弱畸精子症;
2、不可逆的梗阻性无精子症;
3、生精功能障碍(排除遗传缺陷疾病所致);
4、免疫性不育;
5、常规试管婴儿受精失败,或受精率极低;
6、精子顶体异常等情况者。

第三代试管婴儿(PGD)
植入前胚胎遗传学诊断指从体外受精的胚胎取部分细胞进行基因检测,排除致病基因的胚胎后才移植。
1、染色体数目或结构异常的患者;
2、夫妻一方为性连锁遗产病的携带者(例如血友病、假肥大性肌营养不良)
3、可进行基因诊断的单基因病患者或者携带者等。





